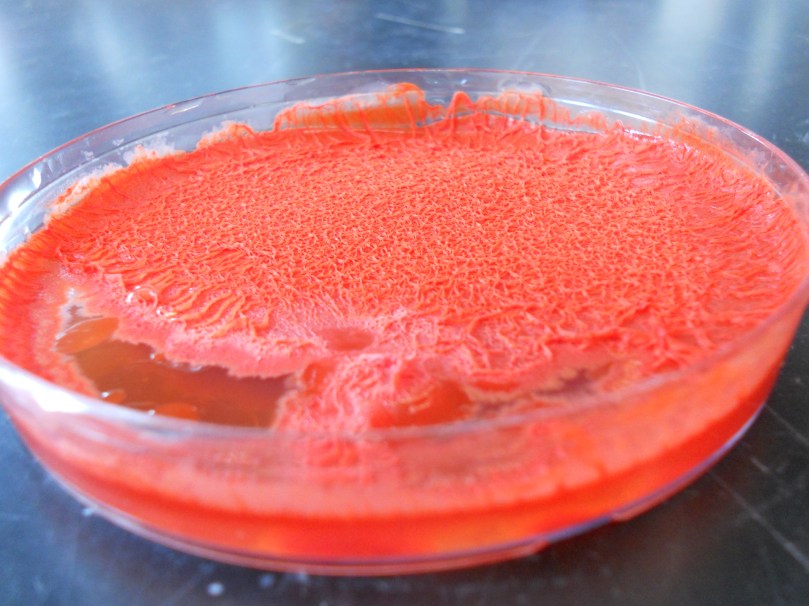
Gallery Image
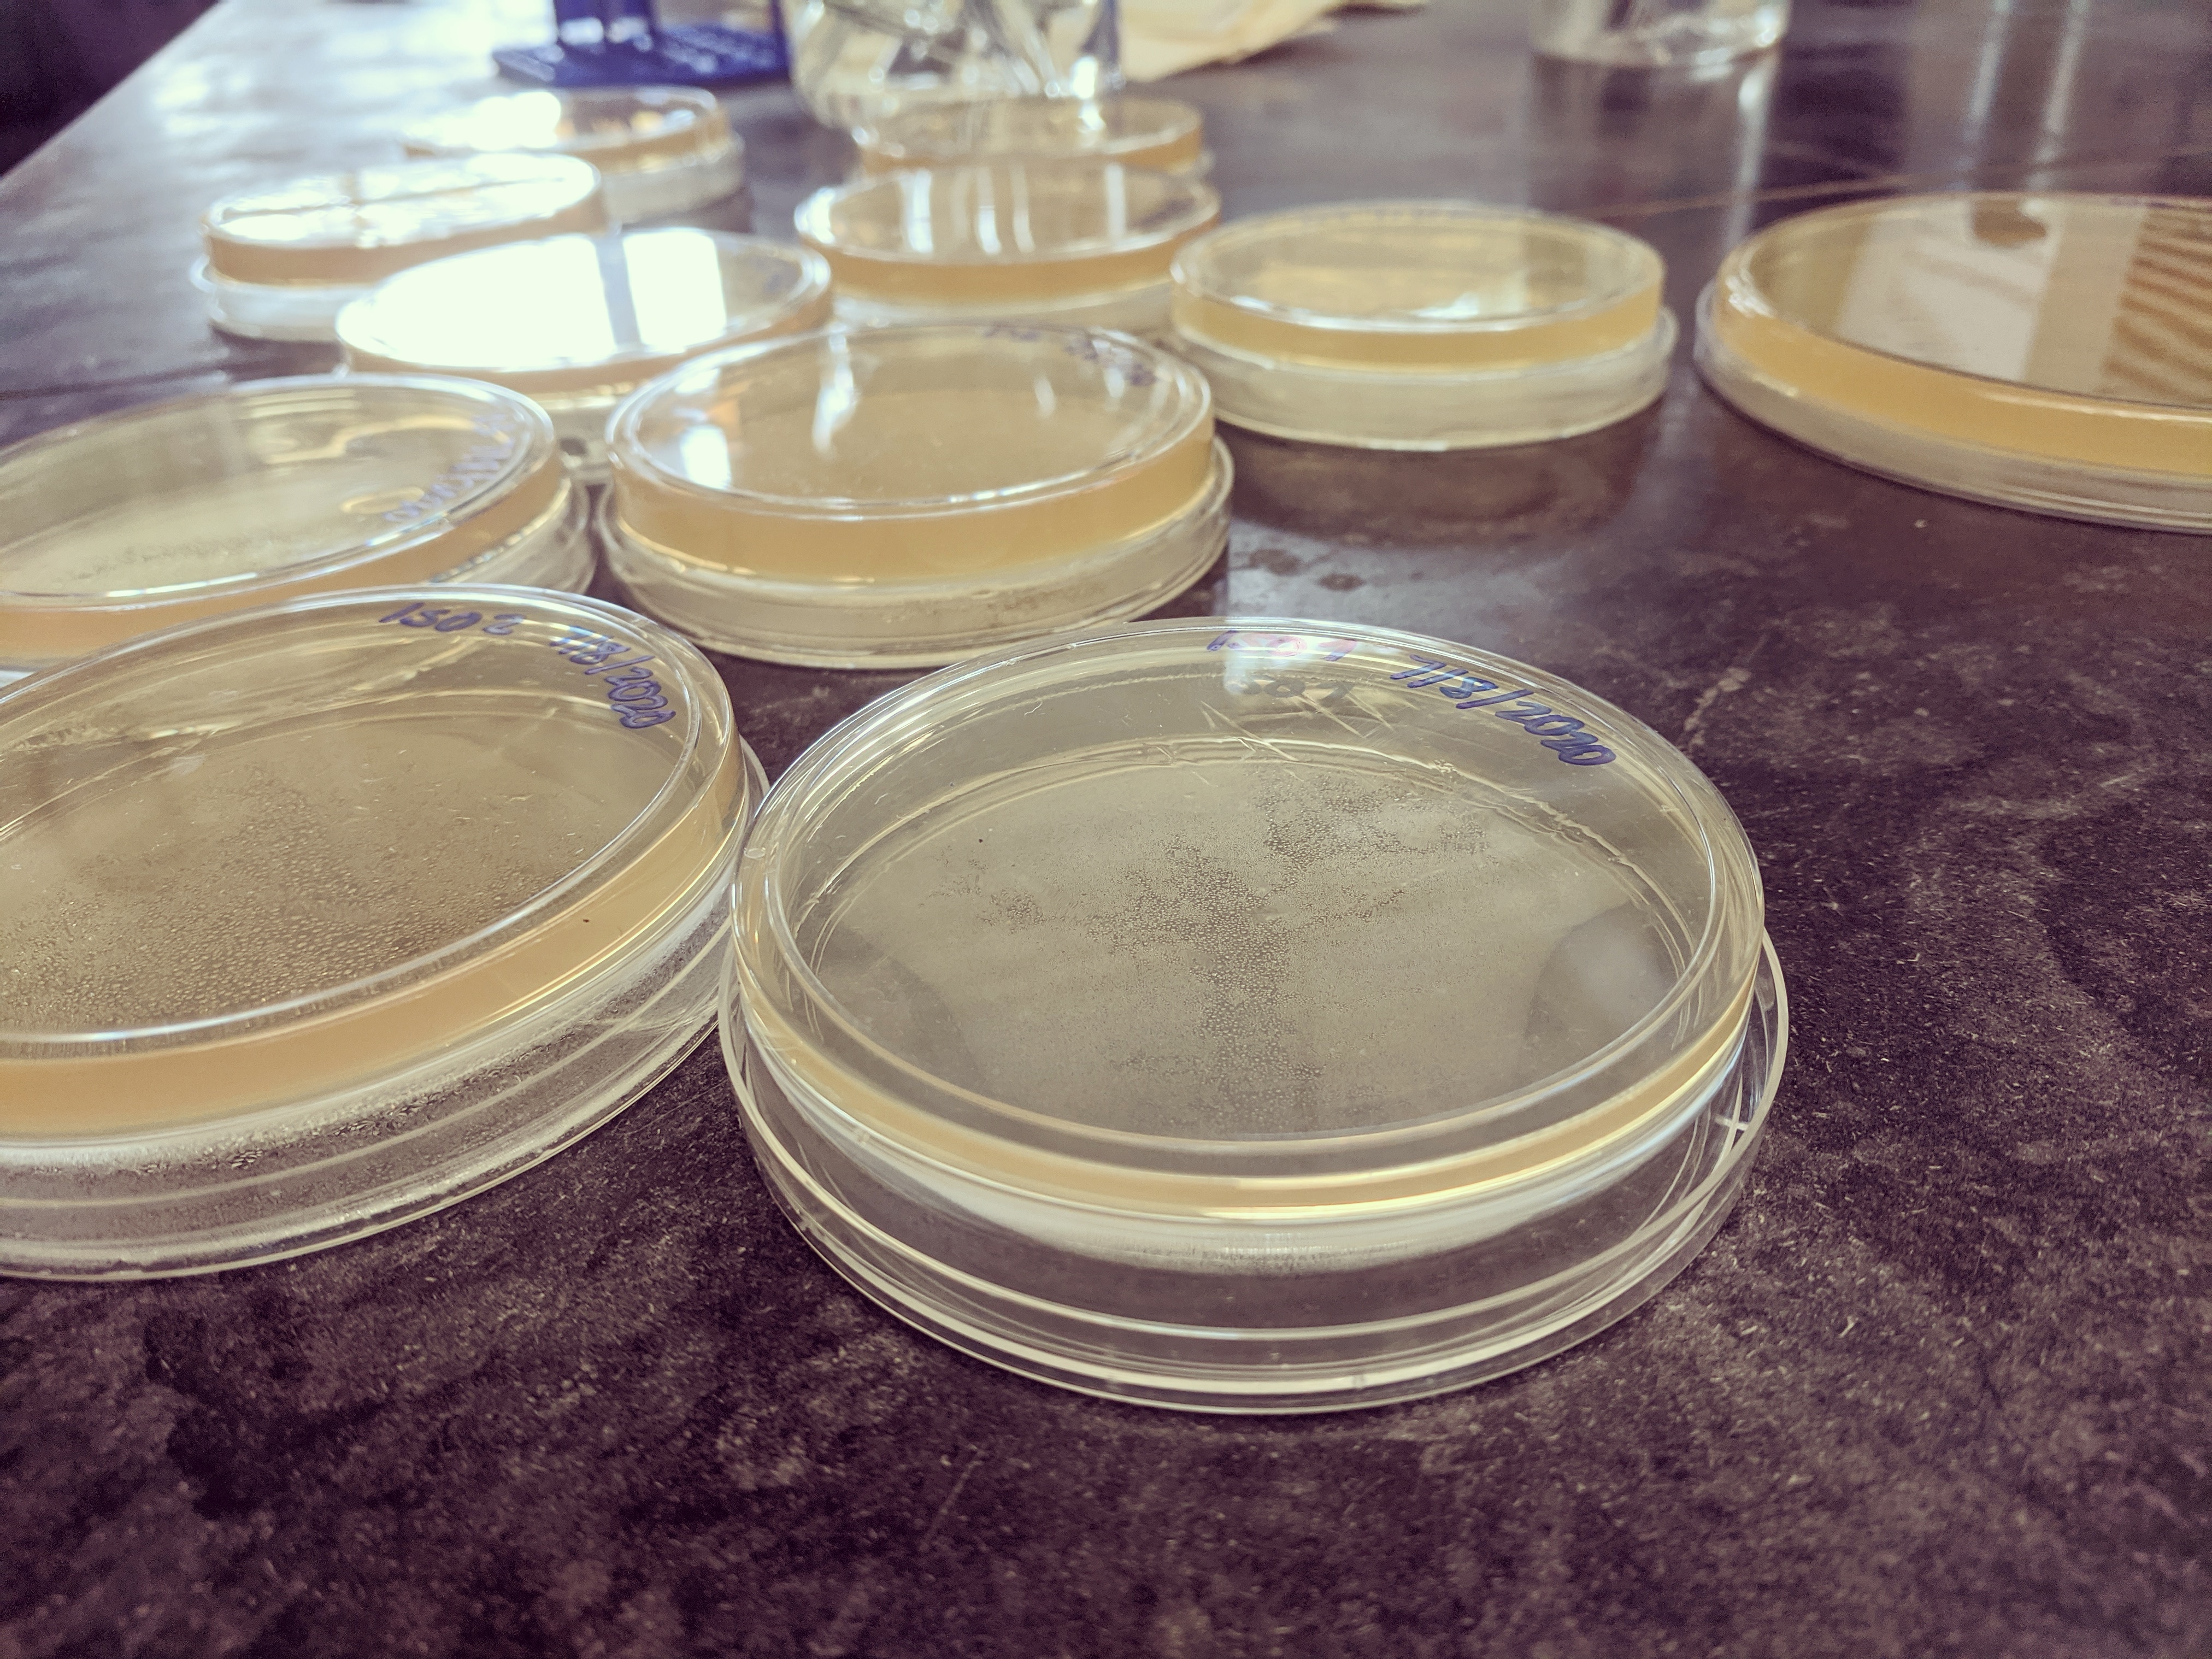
A close-up picture of petri dishes containing a light yellow film of microbes.

The Ishaq Lab established at the University of Maine, Orono in the School of Food and Agriculture in Sept 2019, when Dr. Sue Ishaq, Principal Investigator, joined the UMaine faculty in the Animal and Veterinary Sciences unit of the School of Food and Agriculture. The Ishaq lab focuses on the microbiome of humans and animals, including mouse models, aquacultured marine animals, wild animals, and livestock.
What we research
The majority of our work focuses on host-microbe interactions, and asks questions about how animals acquire their microbes, from where, and how their microbial communities are changed by the lifestyle or environmental conditions of that animal.
Microbial community structure and population dynamics are integral to community function, regardless of the specific ecosystem in which microorganisms are being studied. Dysbiosis in an animal or human host shifts the microbial communities found in or on them, and generally reduces diversity. If those disturbances to the community are repetitive there is a risk for system crash. Whether it be digesta, water, soil, or dust, we can use dynamic sources of microorganisms as in situ tools to cultivate a desired community.
We study many different animal species, ecosystems, or situations related to microbes, but we much of my work centers on the importance of 1) biogeography – the spatial location of microbiota in a host and how this affects host-microbe interactions, 2) environmental contexts as determinants of the host microbiota, 3) synthesizing a new research and education discipline: ‘microbes and social equity’, and 4) leveraging collaboration to improve the insight gained from research and education.
Why we research
Human intervention changes microbial communities, and in most cases, it simplifies them – microbial diversity is lost. We can see this in the gut of humans and animals that are considered Westernized, urban, or domesticated as compared to their counterparts who still interact with their natural surroundings on a regular basis.
But, our understanding of microbial ecosystems and how to manipulate them is still in an early state. Our goal is to increase our understanding of microbial communities involved with animals, and particularly in agriculture, aquaculture, and diet/food settings. We aim to tie this work into larger research collaborations to improve the sustainability of agriculture to promote the health of our natural environments.
Science communication
The Ishaq Lab philosophy is that researchers have an obligation to share and disseminate the results of their work, and to engage both the general public and the specific groups that may benefit from those findings. As such, this site will strive to create a connection between science and, well, you! Microbiology is for sharing! And so is molecular genetics, and bioinformatics, and astrophysics…

Dear Dr. Ishaq,
Thanks I have seen your area of research and interest. We can definately collaborate in plant and soil related research.
LikeLike
Hi Ashwani, thanks for your interest but I am phasing out my soil collaborations to focus on animal microbes.
LikeLike